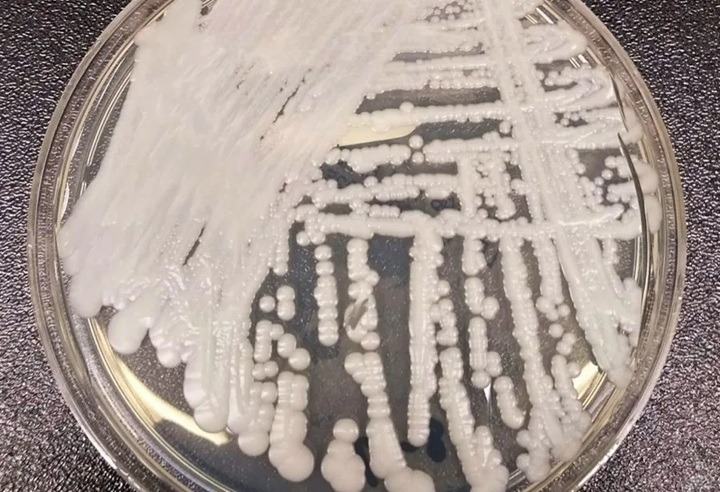

Sesap confirma nova contaminação por superfungo em hospital de Natal
A Secretaria de Estado da Saúde Pública do Estado (Sesap) confirmou, nesta quinta-feira (5), um novo caso de contaminação do superfungo candida auris, no Hospital Central Coronel Pedro Germano (Hospital da PM). Essa é o segundo caso registrado no Rio Grande do Norte neste ano.
O Candida auris (C. auris) é um fungo emergente que representa uma grave ameaça à saúde global. Ele foi identificado pela primeira vez como causador de doença em humanos em 2009, no Japão, em um caso de otomicose. Desde então, o microrganismo já foi detectado em todos os continentes, com exceção da Antártica.
Também conhecido como “superfungo”, o Candida auris é um agente oportunista, capaz de causar doença principalmente em pessoas imunocomprometidas. Sua capacidade de resistir aos antifúngicos e de se espalhar em ambientes hospitalares exige protocolos rigorosos de controle e prevenção, reforçando a necessidade de monitoramento constante pelas autoridades de saúde.
De acordo com a Agência Nacional de Vigilância Sanitária (Anvisa) e o Ministério da Saúde, cepas de C. auris apresentam resistência a todas as três principais classes de antifúngicos, incluindo fluconazol, anfotericina B e equinocandinas. Essa resistência torna o tratamento de infecções particularmente difícil. Além disso, a identificação do fungo requer métodos laboratoriais específicos, já que ele pode ser confundido com outras espécies de leveduras, como Candida haemulonii e Saccharomyces cerevisiae.
*Com informações de Portal da 98 FM


























